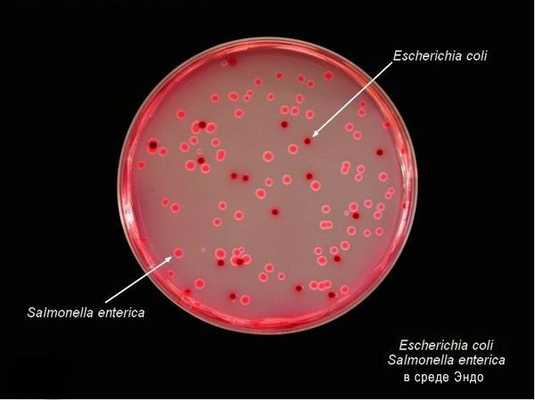
Бактерии в агаре Эндо

Мансонеллез - причины, симптомы, диагностика и лечение
Добавил пользователь Дмитрий К. Обновлено: 11.12.2025
Мансонеллез (mansonellosis) - филяриатоз, характеризующийся аллергическими реакциями, доброкачественным течением.
Мансонеллез распространен в Центральной и Южной Америке, а также в ряде стран Карибского бассейна.
Что провоцирует / Причины Мансонеллеза:
Возбудитель - Mansonella ozzardi. Взрослых паразитов у человека находят редко. Микрофилярии обитают в крови, суточный ритм выхода в периферические сосуды отсутствует.
Размеры самки - 73×0,3 мм, самца - 32 мм, микрофилярии - 173-240×4-5 мкм. Микрофилярии без чехлика. Половозрелые филярии локализуются под серозной оболочкой брюшины, в брыжейке, в полостях тела.
Патогенез (что происходит?) во время Мансонеллеза:
Источник возбудителя и окончательный хозяин - человек, промежуточный переносчик возбудителя и хозяин - мокрецы рода Culicoides и мошки рода Simulium.
Симптомы Мансонеллеза:
Многие специалисты считают этого гельминта непатогенным, однако заражение им сопровождается головной болью, артралгией, лихорадкой, симптомами поражения легких, увеличением лимфоузлов, гепатомегалией, зудом, эозинофилией.
Диагностика Мансонеллеза:
Лечение Мансонеллеза:
К каким докторам следует обращаться если у Вас Мансонеллез:
Вас что-то беспокоит? Вы хотите узнать более детальную информацию о Мансонеллеза, ее причинах, симптомах, методах лечения и профилактики, ходе течения болезни и соблюдении диеты после нее? Или же Вам необходим осмотр? Вы можете записаться на прием к доктору .
Сальмонеллёз
Сальмонеллез - это инфекционное заболевание пищеварительной системы, возникающее в результате заражения бактериями рода Salmonella, сопровождающееся выраженной интоксикацией и дегидратацией, иногда протекающее по типу тифа, либо с септицемией. Наиболее опасными в плане сальмонеллеза являются термически плохо обработанные яица, молочные и мясные продукты. Течение сальмонеллеза может происходить по гастроинтестинальному или генерализованному варианту, возможно бактериовыделение без клинических проявлений. Диагноз сальмонеллеза выставляется при обнаружении сальмонелл в каловых и рвотных массах больного.
Общие сведения
Сальмонеллез - это инфекционное заболевание пищеварительной системы, возникающее в результате заражения бактериями рода Salmonella, сопровождающееся выраженной интоксикацией и дегидратацией, иногда протекающее по типу тифа, либо с септицемией.
Причины
Salmonella - род грамотрицательных, подвижных, факультативно анаэробных, палочковидных микроорганизмов. Относительно устойчивы в окружающей среде. Могут сохранять жизнеспособность в воде до 5 месяцев, в почве до полутора лет, в мясе до полугода, в птичьих тушках до года и более. Около 20 дней сохраняются в молоке, месяц в кефире и четыре - в сливочном масле. В сыре сальмонелла может оставаться в живом виде до года, 3-9 месяцев в яичном порошке и 17-24 дня на скорлупе яиц. Сальмонеллы погибают спустя 5-10 минут при температуре 70 °С, Могут выдерживать некоторое время кипячение, если находятся в толще крупного куска мяса. При варке яиц погибают через 4 минуты. В молоке и мясных продуктах сальмонеллы не только сохраняются, но и активно размножаются, при этом не влияя на органолептические свойства продуктов. Микроорганизмы довольно устойчивы к солению и копчению, а при заморозке увеличивают длительность срока жизни. В настоящее время выделены резидентные (иначе - госпитальные) штаммы сальмонелл, имеющие высокую степень устойчивости к антибиотикотерапии и дезинфицирующим средствам.
Резервуаром и источником сальмонеллеза является домашний скот, птица, некоторые дикие животные. У животных заболевание может протекать как с клиническими проявлениями, так и бессимптомно. Здоровые животные не заболевают сальмонеллезом, к этому склонны особи с ослабленным иммунитетом. Сальмонеллы проникают в кровоток таких животных и обсеменяют органы и ткани. Человек заражается при уходе за больными животными, их забое, употреблении в пищу инфицированных продуктов животного происхождения. Птицы, больные сальмонеллезом, могут загрязнять пометом объекты обстановки и продукты питания. В некоторых случаях (отдельные виды возбудителя) источником инфекции может быть человек. Животные заразны в течение нескольких месяцев, человек может передать инфекцию в период от нескольких дней до трех недель, иногда носительство сохраняется годами.
Сальмонеллез передается по фекально-оральному механизму преимущественно пищевым путем. Основное значение в эпидемиологии сальмонеллеза играют мясные и молочные продукты, птичьи яйца. Водный путь заражения реализуется в случае попадания сальмонелл в источники питьевой воды для скота в животноводческих хозяйствах. Контактно-бытовой путь нередко имеет важное эпидемиологическое значение в случаях внутрибольничных инфекций. В городских условиях возможна реализация воздушно-пылевого пути заражения.
Люди обладают высокой восприимчивостью к сальмонеллезу. Степень тяжести развившейся инфекции зависит от комплекса факторов, как внешних (количество попавших в организм возбудителей, их антигенный состав и биологические особенности), так и внутренних (состояние защитных систем организма человека, сопутствующие патологии, в частности пищеварительной системы). Наиболее тяжело инфекция протекает у младенцев (особенно недоношенных) и лиц пожилого возраста. Постинфекционный иммунитет нестойкий, сохраняется не более года.
Классификация
По клинической картине и степени распространения инфекционный процесс разделяют на гастроинтестинальный, генерализованный сальмонеллез и бактериовыделение. Гастроинтестинальная форма по локализации различается на варианты: гастритический, гастроэнтеритический и гастроэнтероколитический.
Генерализованный сальмонеллез может протекать в виде двух вариантов: тифоподобного и септического. Бактериовыделение может носить острый, хронический и транзитный характер.
Симптомы сальмонеллеза
Инкубационный период сальмонеллеза может длиться от нескольких часов до двух дней. Клинические проявления зависят от варианта заболевания. Наиболее часто встречающейся формой является гастроэнтеритический вариант сальмонеллеза. Характеризуется общей интоксикацией и нарушением водно-солевого обмена. Заболевание начинается остро, с повышения температуры и нарастания признаков интоксикации (головная боль, ломота в мышцах, слабость). Затем в животе возникает боль спастического характера с преимущественной локализацией в верхних отделах живота и пупочной области, тошнота и частая рвота. Вскоре присоединяется диарея, каловые массы довольно быстро приобретают водянистый, пенистый характер, зловонны, иногда отмечается их зеленоватый оттенок. Диарея и рвота имеют различную частоту в зависимости от тяжести течения заболевания. Обилие выделяемой жидкости при рвоте и дефекации ведет к развитию дегидратации.
При физикальном осмотре выявляется бледность кожных покровов, несмотря на лихорадку, иногда отмечается цианоз, язык сухой и покрыт налетом, вздутие живота. При пальпации в животе отмечают урчание, умеренную болезненность. При выслушивании сердца тахикардия, тоны приглушены. Пульс мягкого наполнения, склонность к артериальной гипотензии. Нередко отмечают умеренную олигурию. При тяжелой дегидратации возможно развитие судорог, преимущественно нижних конечностей.
При гастроэнтероколитическом варианте к второму-третьему дню объем испражнений уменьшается, в кале могут обнаруживаться слизь и прожилки крови. Пальпация живота выявляет болезненность и спазм толстого кишечника, дефекация может сопровождаться тенезмами. Гастритический вариант имеет наиболее легкое и кратковременное течение, встречается сравнительно редко. Он также характеризуется острым началом, менее выраженной интоксикацией, многократной рвотой. Боль локализуется преимущественно в области эпигастрия, диарея не развивается. При гастроинтестинальной форме сальмонеллеза степень тяжести определяется по выраженности интоксикационного и дегидратационного синдромов. Степень интоксикации обычно характеризует температура тела, которая может варьироваться от субфебрилитета до выраженной лихорадки.
Генерализованная форма может протекать по тифоподобному варианту, при этом первоначально часто отмечаются гастроэнтеральные явления. В последующем по стиханию тошноты, рвоты и диареи нарастает лихорадка и признаки интоксикации (головная боль, бессонница, выраженная слабость), при этом лихорадка приобретает постоянный или волнообразный характер. При осмотре больного иногда могут отмечать элементы геморрагической сыпи на коже, на 3-5 день обнаруживается гепатоспленомегалия. Характерна умеренная артериальная гипотензия, относительная брадикардия. Клиническая картина напоминает таковую при брюшном тифе.
Септический вариант сальмонеллеза также зачастую начинается с желудочно-кишечной клиники, в последующем сменяющейся выраженной стойкой ремиттирующей лихорадкой, тахикардией, ознобами и интенсивным потоотделением при понижении температуры. Имеет место гепатолиенальный синдром. Заболевание протекает тяжело, длительно, может способствовать развитию вторичных очагов гнойного воспаления в легких, почках и мочевом пузыре (пиелонефрит, цистит), эндокардитов, абсцессов и флегмон. Иногда отмечают воспаление радужки.
После перенесенного сальмонеллеза, вне зависимости от его формы, некоторые больные продолжают выделять возбудителя (бактериовыделение) до месяца. Если бактериовыделение затягивается более трех месяцев, его признают хроническим. К тяжелым осложнениям с высокой вероятностью летального исхода относят инфекционно-токсический шок, который сопровождается отеком легких и головного мозга, сердечно-сосудистой, почечной и надпочечниковой недостаточностью. Генерализованные формы чреваты развитием гнойных осложнений.
Диагностика сальмонеллеза
Для диагностики производят выделение возбудителя из рвотных и каловых масс (при генерализованных формах возбудитель выявляется в бакпосеве крови). Иногда бактерии можно выделить из промывных вод желудка и кишечника, желчи. Для идентификации возбудителя производят посев на питательные среды. Серологическая диагностика производится с помощью РНГА, РКА, РЛА, ИФА, РИА.
Степень дегидратации определяют на основании анализа данных о гематокрите, вязкости крови, кислотно-щелочном состоянии и балансе электролитов. При развитии осложнений сальмонеллеза необходима консультация кардиолога, уролога, нефролога и других специалистов в зависимости от вида осложнения.
Лечение сальмонеллеза
Больные с тяжелой формой течения или склонные к развитию осложнений подлежат госпитализации, в остальных случаях лечение производится на дому. Желательно первоначально осуществить меры по промыванию желудка и кишечника (сифонные клизмы, энтеросорбенты). Затем осуществляют коррекцию водно-солевого баланса, производя мероприятия по регидратации. Дегидратацию первой и второй степени корректируют с помощью частого дробного приема внутрь солевых растворов. Более тяжелая степень обезвоживания может потребовать внутривенной инфузионной терапии изотоническими полиионными растворами.
Дезинтоксикационную терапию коллоидными растворами или 10% раствором декстрана проводят только после восстановления водно-электролитного гомеостаза. Признаки выраженного метаболического ацидоза являются показанием к назначению внутривенного введения бикарбоната натрия.
Антибиотикотерапия показана при генерализованной форме заболевания. Назначают препараты группы фторхинолонов, хлорамфеникол, доксициклин. Для лечения гастроинтестинальных форм заболевания антибиотики применяют только в случаях стойкой к другим терапевтическим мерам инфекции. При гастроинтестинальной форме хороший эффект дает назначение ферментных препаратов (панкреатин, сухая желчь). В острый период заболевания больным прописана диета №4, после стихания кишечных проявлений - №13.
Профилактика сальмонеллеза
Общая профилактика сальмонеллеза включает мероприятия по обеспечению санитарно-гигиенических условий при содержании, убое скота и птицы, обработке туш и продуктов животного происхождения, приготовлении блюд из них на предприятиях общественного питания и пищевых производствах. А также меры по контролю над заболеваемостью сельскохозяйственных животных и птиц. Индивидуальная профилактика заключается в тщательной кулинарной обработке продуктов животного происхождения, соблюдение сроков хранения пищи.
Мер специфической профилактики сальмонеллеза (вакцинации) не предусмотрено в силу антигенной неоднородности возбудителя и нестойкости иммунитета. Экстренная профилактика в очаге инфекции при внутрибольничных вспышках производится с помощью лечебного сальмонеллезного бактериофага.
Мансонеллёз
Мансонеллез - паразитарное инфекционное заболевание, вызываемое круглыми червями (нематодами). Самыми частыми клиническими симптомами являются кожные высыпания, артриты и нарушения оттока лимфы. Для гельминтоза также характерна лихорадка, воспаление лимфатических узлов, увеличение размеров печени. Диагностика патологии заключается в обнаружении возбудителя в мазке крови. Лечение подразумевает использование этиотропных противопаразитарных препаратов, средств симптоматической терапии (десенсибилизирующие, анальгетики, противовоспалительные, антигистаминные и др.).
МКБ-10
Мансонеллез относится к нематодозам, поражающим серозные оболочки. Описание данного гельминта и вызываемой им патологии в 1897 году впервые опубликовал шотландский врач Мансон, в честь которого и был назван возбудитель. В 1929 году американский паразитолог Фауст подтвердил открытие Мансона. Гельминтоз широко распространен в странах Индии, Южной и Центральной Америки. Болеют преимущественно мужчины (около 60% случаев) старше 55 лет. Патология встречается круглогодично, наиболее часто атаки переносчиков (мокрецов) на человека происходят в вечернее либо утреннее время, укусы преимущественно локализуются в верхней половине туловища.
Причины мансонеллеза
Возбудитель инфекции - нематода Mansonella ozzardi. Самки этого вида достигают в длину 80 мм и более, длинник тела личинки (микрофилярии) составляет около 0,2 мм. Источником гельминтоза служат больные люди, которые становятся окончательными хозяевами мансонелл. Промежуточный (личиночный) этап возбудитель проходит в теле кровососущих мокрецов (семейство двукрылых), являющихся переносчиками болезни. Выплод мокрецов происходит во влажной почве, заросших водоемах, они активны в сумерках и в безветренную погоду. Другими переносчиками инфекции могут быть черные мухи рода Симилиум. Инфицирование возникает при укусе и кровососании мокрецов, теоретически может наблюдаться при переливании крови, трансплантации органов, использовании нестерильного инструмента, шприцов в медицинских и немедицинских целях. В группу риска входят туристы, дети, сельскохозяйственные работники, охотники.
Патогенез
Патогенез мансонеллеза изучен недостаточно. При проникновении через кожные покровы со слюной мокреца микрофилярии попадают в кровоток и лимфоток окончательного хозяина. По кровеносным и лимфатическим сосудам с током жидкости личинки транспортируются в брыжейку кишечника, перикард, лимфатические узлы, суставные полости, соединительную ткань, где находятся до наступления половой зрелости. Взрослые особи гельминта сохраняют свою активность в органах, размножаются, выпуская микрофилярий в кровь. Циркуляция личинок в крови обеспечивает дальнейшую органную инвазию паразита; четкого суточного ритма появления микрофилярий в кровотоке не описывается. Вместе с личинками происходит выброс токсичных продуктов обмена гельминтов, что обусловливает сенсибилизацию организма. Процесс инвазивного массивного воспаления в лимфоузлах, распространения по лимфатическим сосудам приводит к нарушениям тока лимфы.
Условное разделение мансонеллеза по клиническим проявлениям основывается на классификации по ведущему синдрому. Практически постоянное нахождение микрофилярий в системе кровообращения в течение длительного времени может затрагивать все органы; описаны случаи выделения возбудителя из ликвора. Различают следующие разновидности болезни:
- Аллергическая. Не имеет ярких клинических симптомов, в общем анализе крови при плановом обследовании может проявляться выраженной эозинофилией.
- Суставная. Наблюдаются боли, отеки, покраснение и вынужденное ограничение движений в крупных суставах.
- Кожная. Протекает с образованием зудящих высыпаний на коже, которые самостоятельно исчезают через некоторое время, затем вновь появляются.
- Смешанная. Наличие в клинике признаков поражения двух и более органов и систем предполагает массивную инвазию либо долговременное течение гельминтоза.
Симптомы мансонеллеза
Точная длительность инкубационного периода неизвестна, предположительно колеблется от нескольких дней до полугода. Симптоматика неспецифична, иногда практически отсутствует. Больные могут предъявлять жалобы на длительный субфебрилитет (37,5-38° C), слабость, умеренные головные боли, появление кожных высыпаний, зуда. Коленные, локтевые, голеностопные, лучезапястные, плечевые суставы увеличиваются в размерах, появляются боли совершении привычных движений. Кожа над суставами становится горячей и гиперемированной. Пациенты щадят конечности, принимают необычные позы для уменьшения болевого синдрома. При усугублении лимфостаза формируются отеки ног и лица, снижается чувствительность, нижние конечности становятся прохладными, изменяются их внешние очертания, ходьба причиняет боль. Возможно случайное травмирование кожи и возникновение вторичных бактериальных гнойных процессов (флегмоны, абсцесса), которые трудно поддаются лечению из-за нарушения циркуляции лимфы.
Осложнения
Наличие осложнений, прежде всего, свидетельствует о давности процесса и несвоевременной медицинской помощи. Частыми последствиями мансонеллеза являются гидроцеле, слоновость, хронические артриты крупных суставов, гнойные лимфадениты, фурункулез, рожа, кератит. Единичные случаи проникновения мансонелл в спинномозговую жидкость сопровождаются риском развития нейрокогнитивных расстройств, воспаления мозговых оболочек и вещества головного мозга.
Диагностика
Показаны консультации инфекциониста, дерматовенеролога, ревматолога. При наличии симптомов поражения ЦНС и глаз требуется осмотр офтальмолога и невролога. Важным звеном диагностического поиска является подробный сбор эпидемиологического анамнеза. Критерии, позволяющие подтвердить предполагаемый диагноз, включают в себя:
- Объективный осмотр. При физикальном исследовании могут обнаруживаться кожные высыпания (эритемы, папулы), расчесы (видимый критерий наличия зуда), изменения суставов (отек, гиперемия, локальная гипертермия, ограничение произвольных движений). Иногда при пальпации выявляется диффузное повышение чувствительности в подвздошных областях. Определяется наличие отеков лица, конечностей, лимфедема, в запущенных случаях - фибредема.
- Лабораторные исследования. Общий анализ крови подтверждает лейкоцитоз с выраженной эозинофилией, базофилией, увеличением СОЭ. Биохимические показатели в пределах нормы; возможно увеличение уровня мочевой кислоты, СРБ. Изменения в клиническом анализе мочи обычно отсутствуют, в редких случаях можно обнаружить скопления эозинофилов. Исследование суставной жидкости подтверждает наличие неспецифического воспаления.
- Выявление инфекционных агентов. Наиболее эффективными методами считаются ПЦР и фильтрация крови через поликарбонатную мембрану. Возможно применение микроскопического исследования толстой капли, тонкого мазков крови, метода Нотта. Осуществляется посев крови на стерильность и гемокультуру. Серологическая диагностика производится с антигенами других возбудителей филяриатозов и глистных инвазий.
- Лучевые методы. Рентгенография грудной клетки выполняется для косвенного подтверждения перикардита, исключения других патологий. На УЗИ визуализируются признаки изменений перикарда. Ультразвуковая диагностика позволяет исключить поражения брюшины, лимфатических узлов иной этиологии (инфекционной, метастатической).
Дифференциальную диагностику проводят с другими глистными инвазиями (онхоцеркоз, вухерериоз, лоаоз, акантохейлонематоз, стрептоцеркоз, дирофиляриоз, трихинеллез), вирусным гепатитом В, лихорадкой чикунгунья, рожей, туберкулезом, сифилисом, аллергическим дерматитом, артритами, перикардитом, канцероматозом брюшины, ревматизмом, экземой, лимфогранулематозом, псориазом, хронической венозной недостаточностью, первичным и вторичным элефантиазом.
Лечение мансонеллеза
Терапия заболевания проводится в условиях стационара только при тяжелом течении болезни, наличии коморбидной патологии, в детском возрасте, при беременности. Необходимо исключить контакт больного с мокрецами. Диетические рекомендации связаны с отказом от потенциальных пищевых аллергенов (цитрусовые, какао, орехи и другие), употреблением достаточного количества жидкости. Постельный режим необходим до нормализации температуры тела в течение двух суток. При отсутствии сильных болей передвижения не ограничиваются.
Основным этиотропным препаратом длительное время считался диэтилкарбамазин, в исследованиях 2018 года высокую эффективность (исчезновение микрофиляремии у 99,9% больных) показал ивермектин. Симптоматическое лечение включает использование десенсибилизирующих (хлорид, глюконат кальция), дезинтоксикационных (глюкоза, физиологический раствор), антигистаминных (хлоропирамин, дезлоратадин), противовоспалительных средств, анальгетиков. Иммобилизация суставов для уменьшения болей производится путем тугого бинтования, применения бандажей и ортезов.
Прогноз и профилактика
Прогноз гельминтоза благоприятный, при своевременном выявлении и лечении наступает полное выздоровление. Случаи смерти от мансонеллеза не регистрировались, вероятность неблагоприятного исхода выше среди лиц с длительным течением болезни, присоединением осложнений, декомпенсацией хронической патологии. Частое бессимптомное течение способствует длительному нахождению возбудителя в организме. Специфическая профилактика (вакцинация) не разработана. Лицам, выезжающим в эндемичные районы, рекомендована химиопрофилактика заражения (диэтилкарбамазин, ивермектин, доксициклин). Неспецифическая профилактика заключается в использовании защитной одежды, репеллентов, инсектицидов, осушении болотистой местности, санитарной охране водоемов. Противомоскитные сетки на окна малоэффективны, поскольку мокрецы могут проникать сквозь ячейки.
Лоаоз ( Калабарская опухоль )
Лоаоз - это хроническое инфекционное заболевание, вызываемое круглыми червями. Характерным клиническим симптомом является образование ограниченного отечного участка, преимущественно на конечностях, а также поражение слизистых оболочек, чаще конъюнктивы. Висцеральные инвазии встречаются реже. Диагностика болезни заключается в обнаружении возбудителя в крови и тканях, определении антител. Терапия этиотропная (диэтилкарбамазин) и симптоматическая, особое внимание уделяется купированию аллергического компонента заболевания. Хирургическое лечение используется в случае субконъюнктивальной локализации.
Лоаоз (калабарская опухоль) - нематодоз, отличительной особенностью которого является миграция взрослых особей в тканях организма. Возбудитель был открыт в 1778 году французским ученым Гюйо. Заболевание распространено во влажном тропическом климате на территории стран Западной и Центральной Африки, четкой сезонности не имеет. Пораженность местного населения составляет 70-90%, приезжих - до 20%, при этом среди жителей эндемичного региона обычно регистрируется бессимптомное течение патологии. Группами риска являются мужчины, представители негроидной расы, лица в возрасте 30-39 лет, сельскохозяйственные рабочие, лесорубы.
Причины лоаоза
Возбудитель болезни - гельминт, относящийся к круглым червям, Лоа лоа (африканский глазной червь). Паразит является живородящим, раздельнополым. Для развития ему необходима смена хозяев: в организме промежуточного хозяина обитают личинки-микрофилярии, окончательного - половозрелые особи, способные к миграции в тканях. Источником и резервуаром инфекции служит больной человек и, вероятно, некоторые приматы. Путь передачи - трансмиссивный, заражение происходит во время укуса насекомого.
Личиночная стадия лоа лоа проходит в мышечном аппарате переносчика болезни - слепня, этот процесс занимает 7-20 дней, в дальнейшем микрофилярии перемещаются в слюнные железы насекомого. Установлено, что в эндемичных районах Африки пораженность лоа лоа популяции слепней достигает более 5%. Нападение на людей обычно наблюдается днём на территории обитания переносчиков - затененных берегах рек, в зарослях кустарников, лесах; насекомых могут привлекать огонь, дым, движущиеся предметы.
Внедрение микрофилярий в кровеносное русло человека начинается во время атаки слепня. В дальнейшем личинки попадают в капилляры легких, где в течение 6-18 месяцев достигают половой зрелости, проникают в подкожную жировую ткань, конъюнктиву глаз и серозные оболочки, отрождая живых личинок, после чего цикл повторяется. Миграция микрофилярий и наибольшее их количество в периферической крови обычно обнаруживается в дневные часы (12:00-14:00). Вместе с личинками в кровоток попадают токсичные продукты их жизнедеятельности.
В патогенезе клинических проявлений при лоаозе существенную роль играют токсико-аллергические реакции, в которых участвуют специфические иммуноглобулины (E, G3, G4 и другие), вырабатываемые иммунной системой зараженных. Среди больных лоаозом ВИЧ-инфицированных, не получающих антиретровирусные препараты ВААРТ, уровень микрофиляриемии прямо пропорционален росту титра ВИЧ в крови. Это может привести к усугублению течения обоих заболеваний, увеличить риск осложнений и смертельного исхода.
Симптомы лоаоза
Инкубационный период при данном гельминтозе составляет несколько лет, в редких случаях 4 месяца. Заболевание начинается резко, на фоне полного здоровья, с повышения температуры тела более 38° C, озноба, слабости, болей в суставах и костях, сыпи на теле в виде крупных волдырей, боли в конечностях, нарушений чувствительности. При передвижении лоа лоа ощущаются как сами перемещения, так и жгучая боль, зуд. Одновременно на теле (обычно на руках или ногах) образуются безболезненные отечные участки, самостоятельно исчезающие в течение трех дней.
При локализации в области глаз возникает отек век, жжение, чувство движения паразита, обильное слезотечение, интенсивное покраснение; симптомы проходят сразу после проникновения гельминта в область параорбитальной клетчатки. Реже наблюдается попадание лоа лоа в мочеиспускательный канал, что проявляется резкой болью даже в покое, и поражение оболочек головного мозга, при котором главными симптомами становятся затруднение контакта с пациентом, бред, галлюцинации, сильные головные боли, невозможность привести подбородок к груди и др.
Наиболее частыми осложнениями считаются разнообразные проявления отечно-аллергического синдрома, описана водянка яичка, блефароспазм, дилатационная кардиомиопатия, нефропатия, энцефалопатия. Нередко встречаются внутримышечные абсцессы и флегмоны конечностей, обусловленные присоединением вторичной инфекции; с этой же причиной связывают увеит и панофтальмит при глазном поражении, пиелонефрит, цистит, уретрит, орхит и простатит при вовлечении мочеполовой системы.
Гораздо реже встречаются такие осложнения, как кишечная непроходимость, тромбоз мезентериальных сосудов и гипогонадизм. Последнее состояние связывают с высоким уровнем гонадотропина и низким титром сывороточного тестостерона у больных лоаозом мужчин, что становится предпосылкой к формированию вторичного бесплодия. Длительная персистенция гельминта внутри стекловидного тела и высокий уровень микрофиляриемии приводят к кровоизлияниям в сетчатку, отеку диска зрительного нерва, его атрофии и слепоте.
Диагноз лоаоза подтверждается инфекционистом; важен тщательный сбор эпидемиологического анамнеза, в частности, уточняется пребывание в эндемичных по лоаозу странах в течение последнего десятилетия. Обязателен осмотр офтальмолога, по показаниям назначаются консультации других специалистов. Диагностические методы, необходимые для верификации лоаозного поражения, включают следующие методики:
- Физикальное исследование. При объективном осмотре выявляются кожные уртикарные высыпания, отеки конечностей, половых органов, лица и век. В области локализованных отечных образований наблюдается гиперемия, либо (чаще) бледность кожи, зуд. Перкуторно может отмечаться расширение границ сердца, пальпаторно - гепатоспленомегалия. При вовлечении ЦНС определяются общемозговые, очаговые и менингеальные симптомы.
- Осмотр офтальмолога. Наиболее частым является поражение век. При офтальмоскопии слизистая отечна, гиперемирована, с обильным слезотечением. Движущийся круглый червь и экссудат могут быть обнаружены в подслизистой оболочке и передней камере, возможно заращение зрачка; характерны признаки кератита, ретинита, катаракты, атрофии зрительного нерва. Острота зрения при длительном течении лоаоза прогрессивно снижается.
- Лабораторные исследования. В общеклиническом анализе крови - лейкоцитоз, выраженная эозинофилия до 50-70%, вторичная анемия различной степени, незначительное ускорение СОЭ. Наблюдается рост активности АЛТ, АСТ, креатинина и мочевины, гипергаммаглобулинемия, гипоальбуминемия. Иммунограмма характеризуется увеличением иммуноглобулинов класса E. В общем анализе мочи возможна гематурия, протеинурия.
- Выявление инфекционных агентов. Микроскопия крови, взятой в дневное время, позволяет обнаружить личинок лоа лоа. Серологическая диагностика проводится с помощью ИФА. Разработаны экспресс-тесты на определение антител к лоа лоа иммунохроматографическим методом. Проба с диэтилкарбамазином (тест Мазотти) становится положительной при любом филяриатозе, поэтому не считается ни доказательством, ни опровержением лоаоза.
- Инструментальные методики. Рентгенографию органов грудной клетки выполняют для исключения других глистных инвазий; применение МРТ, КТ мягких тканей зрительного аппарата помогает визуализировать гельминта в ретробульбарной клетчатке. УЗИ глазных яблок и орбиты позволяет обнаружить паразита в мягких тканях, недоступных при осмотре. Ультразвуковое исследование подкожной клетчатки, органов брюшной полости рекомендуется с целью дифференциальной диагностики.
Дифференциация осуществляется с аскаридозом, при котором сыпь появляется вместе с поражением кишечника и легких, трихинеллезом, для которого характерны отеки лица и сильные мышечные боли, вухерериозом с типичными лимфангитами, лимфаденитами и сыпью, бругиозом (высыпания, слоновость конечностей). Кроме инфекционной патологии следует отличать лоаоз от укусов насекомых, алиментарной и медикаментозной аллергии, сывороточной болезни, возникающей через 7-14 дней после введения гетерогенных сывороток и иммуноглобулинов.
Лечение лоаоза
Стационарное лечение показано пациентам с глазными симптомами, среднетяжелым и тяжелым течением болезни. Постельный режим назначается до стойкой нормальной температуры тела в течение 3-4 суток. Диетические рекомендации не разработаны; следует исключить алкоголь, никотин, высокоаллергенную и трудноперевариваемую пищу, включить продукты, богатые белком. Важно соблюдать нормальный питьевой режим. Разрешается использование местных противозудных мазей и гелей, во избежание загрязнения расчесов нужно коротко обстричь ногти, чаще мыть руки с мылом.
Этиотропное противогельминтное лечение традиционно заключается в пероральном приеме диэтилкарбамазина, терапевтический курс должен составлять не менее трех недель. В некоторых зарубежных исследованиях предлагалось использование альбендазола и ивермектина, однако самая низкая частота повторных курсов терапии регистрировалась среди пациентов, получавших диэтилкарбамазепин. Применение гормональных препаратов с целью снижения побочных эффектов антигельминтных средств доказанной эффективности не имело.
Выраженная аллергизация организма больного - прямое показание для введения десенсибилизирующих и дезинтоксикационных растворов, антигистаминных средств. В случае выраженных отеков разрешено назначение глюкокортикостероидов, диуретиков и препаратов альбумина. Присоединение гнойных осложнений требует проведения антибиотикотерапии, иногда - хирургического вмешательства. Глазной лоаоз является показанием для оперативного лечения, объем которого определяется индивидуально - от удаления червя до эвисцерации органа зрения.
Прогноз при лоаозе благоприятный за исключением случаев осложненного течения болезни. Летальных случаев зафиксировано не было. Специфическая профилактика (вакцина) на данном этапе развития медицины не разработана. Основные превентивные меры - раннее выявление и изоляция больных, использование противомоскитных сеток в домах и больницах, осушение болот, дезинсекция, применение репеллентов, спреев и одежды из плотных тканей при работах в привычных местах обитания слепней. При длительном нахождении в эндемичном районе рекомендуется принимать профилактические дозы диэтилкарбамазина.
4. A novel rapid test for detecting antibody responses to Loa loa infections/ Bijan Pedram, Valérie Pasquetto, Papa M. Drame// PLoS Negl Trop Dis. - 2017 - №11.
Сальмонеллез - симптомы и лечение
Что такое сальмонеллез? Причины возникновения, диагностику и методы лечения разберем в статье доктора Александрова Павла Андреевича, инфекциониста со стажем в 14 лет.
Над статьей доктора Александрова Павла Андреевича работали литературный редактор Маргарита Тихонова , научный редактор Сергей Федосов и шеф-редактор Лада Родчанина
Определение болезни. Причины заболевания
Сальмонеллёз — это острое инфекционное заболевание желудочно-кишечного тракта с возможностью дальнейшей генерализации процесса (распространением заболевания по всему организму). Причина развития сальмонеллёза — различные серотипы бактерий рода Salmonella. К клиническим характеристикам сальмонеллёза относят синдром общей инфекционной интоксикации, синдром поражения желудочно-кишечного тракта (гастрит, энтерит), синдром обезвоживания, гепатолиенальный синдром (увелечение печени и/или селезёнки) и иногда синдром экзантемы (высыпания).

Возбудитель
семейство — кишечные бактерии (Enterobacteriaceae)
род — Сальмонелла (Salmonella)
Существует 7 подвидов (более 2500 сероваров). Наиболее актуальные серовары: typhimurium, enteritidis, panama, london.
Представлены следующей антигенной структурой:
- О-антиген (соматический, термостабильный);
- H-антиген (жгутиковый, термолабильный);
- К-антиген (поверхностный, капсульный);
- Vi-антиген (антиген вирулентности — степень способности штамма вызвать заболевание; является компонентом О антигена);
- М-антиген (слизистый).
К факторам патогенности (механизмам приспособления бактерий) относятся:
- холероподобный энтротоксин — интенсивная секреция жидкости в просвет кишки;
- эндотоксин (липополисахарид) — общее проявление интоксикации;
- инвазия — заражение.
Тинкториальные свойства: разлагают глюкозу и маннит, образовывая кислоту и газ, продуцируют сероводород. Грамм-отрицательные палочки подвижны, спор и капсул не образуют. Растут на обычных питательных средах, образуя прозрачные колонии, на мясо-пептонном агаре с образованием колоний голубоватого цвета, на среде Эндо образуют прозрачные розовые колонии, на среде Плоскирева — бесцветные мутные, на висмут-сульфитном агаре — чёрные с металлическим блеском.
Высокоустойчивы во внешней среде (без агрессивных воздействий), активно размножаются в мясе и молоке (до 20 суток), в воде сохраняют жизнесособность до 5 мес., в почве — до 9 мес., в комнатной пыли — до 6 мес., в колбасе — до 1 мес., в яйцах — до 3 мес., в фекалиях сохраняются до 4 лет. При 56 °C погибают через 3 минуты, при кипячении мгновенно. Сальмонеллы, которые находятся в куске мяса массой 400 гр и толщиной до 9 см, погибают при его варке за 3,5 часа. Соление и копчение оставляет сальмонелл в живых. Воздействие кислот и хлорсодержащих дезинфицирующих средств вызывает их гибель. В последнее десятилетие появились штаммы сальмонелл, устойчивые ко многим антимикробным препаратам. [2] [5]
Эпидемиология
Зооантропоноз, распространённый повсеместно.
Источники инфекции: домашние животные (сами не болеют), птицы, человек (больной и носитель).
Резервуары инфекции и причина эпидемических вспышек сальмонеллеза: грызуны, дикие птицы, тараканы, улитки, лягушки, змеи.

Механизм передачи: фекально-оральный (пути — алиментарный, т. е. через органы ЖКТ, водный, контактно-бытовой). В основном источниками заражения являются птицы, яйца и молочные продукты. Инфицирующая доза 10*5-10*8 микробных тел.
Факторы риска
- детский возраст до 5 лет;
- возраст до 12 месяцев, особенно высока вероятность заболеть без грудного вскармливания;
- иммунодефицит (в основном у младенцев и лиц старше 65 лет, а так же у пациентов с ВИЧ в стадии СПИДа, принимающих иммунодепрессивные препараты);
- регулярный приём препаратов, снижающих кислотность желудка;
- употребление сырого и недостаточно термически обработанного мяса, молочных продуктов и яиц;
- частый контакт с животными с несоблюдением правил гигиены;
- посещение стран с низким уровнем жизни.
В России в 2016 г. заболеваемость была - 26 на 100 тыс. населения, у детей в до 14 лет - 71 на 100 тыс. Для сравнения в США среднегодовая заболеваемость — 15 на 100 тыс. (1,35 миллиона заболеваний, 26 500 госпитализаций и 420 смертей ежегодно). Иммунитет строго типоспецифичен (возможно многократное инфицирование различными штаммами) и непродолжителен [2] [6] [9] [10] .
При обнаружении схожих симптомов проконсультируйтесь у врача. Не занимайтесь самолечением - это опасно для вашего здоровья!
Инкубационный период — от 6 часов (при алиментарном заражении) до 3 суток. При внутрибрюшном заражении (искусственно) — до 8 дней.
Начало заболевания острое (т. е. развитие основных синдромов происходит в первые сутки заболевания).
Читайте также:
